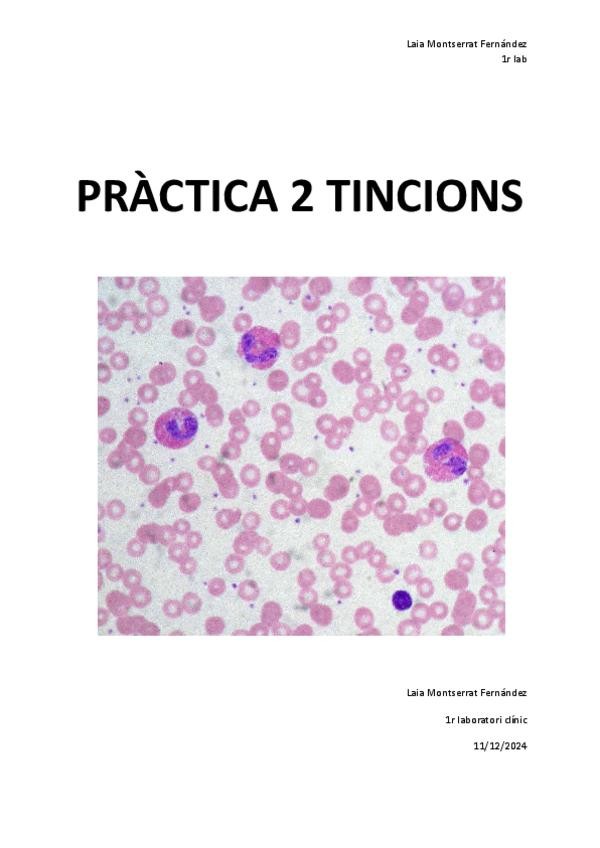

@laiaa_06
10 Publicaciones
44 Interacciones
1 Seguidores
0 Siguiendo
Lista de publicaciones de laiaa_06
He publicado nuevos apuntes de Biología: Temari-biotecnologia-SELE.pdf
He publicado nuevos apuntes de Lengua Castellana y Literatura II: Resumen-figuras-retoricas-PAU-24.pdf
He publicado nuevos apuntes de Biología: Resum-complet-metabolisme-PAU.pdf
He publicado nuevos practicas de Análisis Bioquímico: Practica-determinacio-sucre-begudes-mitjancant-refractometria.pdf
He publicado nuevos practicas de Biología Molecular y Citogenética: Practica-Extraccio-DNA-Saliva.pdf
He publicado nuevos practicas de Biología Molecular y Citogenética: Practica-observacio-cellules-cancerigenes.pdf
He publicado nuevos practicas de Técnicas de análisis hematológico: Practica-temps-de-protrombina-TP.pdf
He publicado nuevos practicas de Técnicas de análisis hematológico: Practica-hematocrit-hematologia.pdf
He publicado nuevos practicas de Técnicas de análisis hematológico: Practica-2-tincions-hematologia.pdf
En aquest PDF trobareu un recull de les justificacions més comuns que demanen a l'examen de quimica de la sele (PAU 2025)